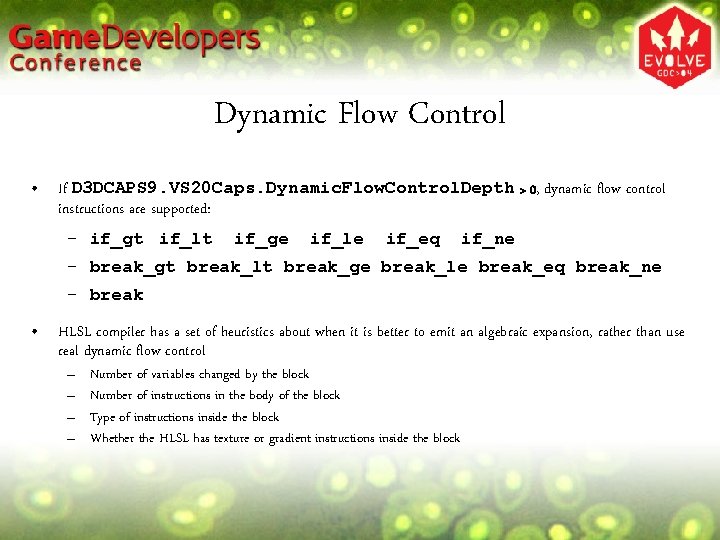
Dynamic Flow Control • If D 3 DCAPS 9. VS 20 Caps. Dynamic. Flow.

Direct 3 D Shader Models Jason Mitchell ATI

- Slides: 41
Direct 3 D Shader Models Jason Mitchell ATI Research
Outline • Vertex Shaders – Static and Dynamic Flow control • Pixel Shaders – ps_2_x – ps_3_0
Shader Model Continuum • • First Thirdgenerationshading • • • Fixed Longer point, programs limited range • • • Short Dynamic asm Flow programs control • ps_1_1 – ps_1_3 ps_1_4 vs_1_1 Second generation Floating point Longer programs / HLSL ps_2_0 ps_2_b ps_2_a ps_3_0 vs_2_a vs_3_0 First generation • • Third generation shading Limited constant store • • Dynamic flow control • No flow control • Second generation • More constant store You Here • Are. Some flow control
Tiered Experience • PC developers have always had to scale the experience of their game across a range of platform capabilities • Often, developers pick discrete tiers of experience – Direct. X 7, Direct. X 8, Direct. X 9 is one example • Shader-only games are in development • Starting to see developers target the three levels of shader support as the distinguishing factor among the tiered experience for their users
Caps in addition to Shader Models • In Direct. X 9, devices can express their abilities via a base shader version plus some optional caps • At this point, the only “base” shader versions beyond 1. x are the 2. 0 and 3. 0 shader versions • Other differences are expressed via caps: – – D 3 DCAPS 9. PS 20 Caps D 3 DCAPS 9. VS 20 Caps D 3 DCAPS 9. Max. Pixel. Shader 30 Instruction. Slots D 3 DCAPS 9. Max. Vertex. Shader 30 Instruction. Slots • This may seem messy, but it’s not that hard to manage given that you all are writing in HLSL and there a finite number of device variations in the marketplace • Can easily determine the level of support on the device by using the D 3 DXGet*Shader. Profile() routines
Compile Targets / Profiles • Whenever a new family of devices ships, the HLSL compiler team may define a new target • Each target is defined by a base shader version and a specific set of caps • Existing compile targets are: – Vertex Shaders • vs_1_1 • vs_2_0 and vs_2_a • vs_3_0 – Pixel Shaders • ps_1_1, ps_1_2, ps_1_3 and ps_1_4 • ps_2_0, ps_2_b and ps_2_a • ps_3_0
2. 0 Vertex Shader HLSL Targets • vs_2_0 – 256 Instructions – 12 temporary registers – Static flow control (Static. Flow. Control. Depth = 1) • vs_2_a – – – 256 Instructions 13 temporary registers Static flow control (Static. Flow. Control. Depth = 1) Dynamic flow control (Dynamic. Flow. Control. Depth cap = 24) Predication (D 3 DVS 20 CAPS_PREDICATION)
vs_2_0 Registers • Floating point registers – 16 Inputs (vn) – 12 Temps (rn) – At least 256 Constants (cn) • Cap’d: Max. Vertex. Shader. Const • Integer registers – 16 Loop counters (in) • Boolean scalar registers – 16 Control flow (bn) • Address Registers – 4 D vector: a 0 – Scalar loop counter (only valid in loop): a. L
Vertex Shader Flow Control • Goal is to reduce shader permutations, allowing apps to manage fewer shaders – The idea is to control the flow of execution through a relatively small number of key shaders • Code size reduction is a goal as well, but code is also harder for compiler and driver to optimize • Static Flow Control – Based solely on constants – Same code path for every vertex in a given draw call • Dynamic Flow Control – Based on data read in from VB – Different vertices in a primitive can take different code paths
Static Flow Control Instructions • Conditional – if…else…endif • Loops – loop…endloop – rep…endrep • Subroutines – call, callnz – ret
Conditionals • Simple if…else…endif construction based on one of the 16 constant bn registers • May be nested • Based on Boolean constants set through Set. Vertex. Shader. Constant. B() if b 3 // Instructions to run if b 3 TRUE else // Instructions to run otherwise endif
Static Conditional Example COLOR_PAIR Do. Dir. Light(float 3 N, float 3 V, int i) { COLOR_PAIR Out; float 3 L = mul((float 3 x 3)mat. View. IT, -normalize(lights[i]. v. Dir)); float Ndot. L = dot(N, L); Out. Color = lights[i]. v. Ambient; Out. Color. Spec = 0; if(Ndot. L > 0. f) { //compute diffuse color b. Specular Out. Color += Ndot. L * lights[i]. v. Diffuse; is a boolean declared at global scope The interesting part //add specular component if(b. Specular) { float 3 H = normalize(L + V); // half vector Out. Color. Spec = pow(max(0, dot(H, N)), f. Material. Power) * lights[i]. v. Specular; } } return Out; }
Result. . . if b 0 mul mad mad dp 3 rsq mad nrm dp 3 max pow mul else mov endif. . . r 0. xyz, v 0. y, c 11 r 0. xyz, c 10, v 0. x, r 0. xyz, c 12, v 0. z, r 0. xyz, c 13, v 0. w, r 4. x, r 0 r 0. w, r 4. x r 2. xyz, r 0, -r 0. w, r 0. xyz, r 2 r 0. x, r 0, r 1. w, r 0. x, c 23. x r 0. w, r 1. w, c 21. x r 1, r 0. w, c 5 r 1, c 23. x r 0 r 0 r 2 Executes only if b. Specular is TRUE
Two kinds of loops • Must be completely inside an if block, or completely outside of it • loop a. L, in – – – in. x - Iteration count (non-negative) in. y - Initial value of a. L (non-negative) in. z - Increment for a. L (can be negative) a. L can be used to index the constant store No nesting in vs_2_0 • rep in – in - Number of times to loop – No nesting
Loops from HLSL • The D 3 DX HLSL compiler has some restrictions on the types of for loops which will result in asm flow-control instructions. Specifically, they must be of the following form in order to generate the desired asm instruction sequence: for(i = 0; i < n; i++) • This will result in an asm loop of the following form: rep i 0. . . endrep • • In the above asm, i 0 is an integer register specifying the number of times to execute the loop The loop counter, i 0, is initialized before the rep instruction and incremented before the endrep instruction.
Static HLSL Loop. . . Out. Color = v. Ambient. Color; // Light computation for(int i = 0; i < i. Light. Dir. Num; i++) // Directional Diffuse { float 4 Col. Out = Do. Dir. Light. Diffuse. Only(N, i+i. Light. Dir. Ini); Out. Color += Col. Out; } . . . Out. Color *= v. Material. Color; // Apply material color Out. Color = min(1, Out. Color); // Saturate
Result vs_2_0 def c 58, 0, 9, 1, 0 dcl_position v 0 dcl_normal v 1. . . rep i 0 add r 2. w, r 0. w, c 57. x mul r 2. w, c 58. y mova a 0. w, r 2. w nrm r 2. xyz, c 2[a 0. w] mul r 3. xyz, -r 2. y, c 53 mad r 3. xyz, c 52, -r 2. x, r 3 mad r 2. xyz, c 54, -r 2. z, r 3 dp 3 r 2. x, r 0, r 2 slt r 3. w, c 58. x, r 2. x mul r 2, r 2. x, c 4[a 0. w] mad r 2, r 3. w, r 2, c 3[a 0. w] add r 1, r 2 add r 0. w, c 58. z endrep mov r 0, r 1 mul r 0, c 55 min o. D 0, r 0, c 58. z Executes once for each directional diffuse light
Subroutines • Can only call forward • Can be called inside of a loop – a. L is accessible inside that loop • No nesting in vs_2_0 or vs_2_a – See Static. Flow. Control. Depth member of D 3 DVSHADERCAPS 2_0 for a given device • Limited to 4 in vs_3_0
Subroutines • Currently, the HLSL compiler inlines all function calls • Does not generate call / ret instructions and likely won’t do so until a future release of Direct. X • Subroutines aren’t needed unless you find that you’re running out of shader instruction store
Dynamic Flow Control • If D 3 DCAPS 9. VS 20 Caps. Dynamic. Flow. Control. Depth > 0, dynamic flow control instructions are supported: – if_gt if_lt if_ge if_le if_eq if_ne – break_gt break_lt break_ge break_le break_eq break_ne – break • HLSL compiler has a set of heuristics about when it is better to emit an algebraic expansion, rather than use real dynamic flow control – – Number of variables changed by the block Number of instructions in the body of the block Type of instructions inside the block Whether the HLSL has texture or gradient instructions inside the block
Obvious Dynamic Early-Out Optimizations • Zero skin weight(s) – Skip bone(s) • Light attenuation to zero – Skip light computation • Non-positive Lambertian term – Skip light computation • Fully fogged pixel – Skip the rest of the pixel shader • Many others like these…
Dynamic Conditional Example COLOR_PAIR Do. Dir. Light(float 3 N, float 3 V, int i) { COLOR_PAIR Out; float 3 L = mul((float 3 x 3)mat. View. IT, -normalize(lights[i]. v. Dir)); float Ndot. L = dot(N, L); Out. Color = lights[i]. v. Ambient; Out. Color. Spec = 0; if(Ndot. L > 0. f) { //compute diffuse color Out. Color += Ndot. L * lights[i]. v. Diffuse; Dynamic condition which can be different at each vertex The interesting part //add specular component if(b. Specular) { float 3 H = normalize(L + V); // half vector Out. Color. Spec = pow(max(0, dot(H, N)), f. Material. Power) * lights[i]. v. Specular; } } return Out; }
Result Executes only if N. L is positive dp 3 r 2. w, r 1, r 2 if_lt c 23. x, r 2. w if b 0 mul r 0. xyz, v 0. y, c 11 mad r 0. xyz, c 10, v 0. x, mad r 0. xyz, c 12, v 0. z, mad r 0. xyz, c 13, v 0. w, dp 3 r 0. w, r 0 rsq r 0. w, r 0. w mad r 2. xyz, r 0, -r 0. w, nrm r 0. xyz, r 2 dp 3 r 0. w, r 0, r 1 max r 1. w, r 0. w, c 23. x pow r 0. w, r 1. w, c 21. x mul r 1, r 0. w, c 5 else mov r 1, c 23. x endif mov r 0, c 3 mad r 0, r 2. w, c 4, r 0 else mov r 1, c 23. x mov r 0, c 3 endif r 0 r 0 r 2
Hardware Parallelism • This is not a CPU • There are many shader units executing in parallel – These are generally in lock-step, executing the same instruction on different pixels/vertices at the same time – Dynamic flow control can cause inefficiencies in such an architecture since different pixels/vertices can take different code paths • Dynamic branching is not always a performance win • For an if…else, there will be cases where evaluating both the blocks is faster than using dynamic flow control, particularly if there is a small number of instructions in each block • Depending on the mix of vertices, the worst case performance can be worse than executing the straight line code without any branching at all
Predication • One way around the parallelism issue • Effectively a method of conditionally executing code on a per-component basis, or you can think of it as a programmable write mask • Optionally supported on {v|p}s_2_0 by setting D 3 D{V|P}S 20 CAPS_PREDICATION bit • For short code sequences, it is faster than executing a branch, as mentioned earlier • Can use fewer temporaries than if…else • Keeps shader units in lock-step but gives behavior of data-dependent execution – All shader units execute the same instructions
if…else…endif vs. Predication • You’ll find that the HLSL compiler does not generate predication instructions • This is because it is easy for a hardware vendor to map if…else…endif code to hardware predication, but not the other way around
vs_3_0 • Basically vs_2_0 with all of the caps • No fine-grained caps like in vs_2_0. Only one: – Max. Vertex. Shader 30 Instruction. Slots (512 to 32768) • More temps (32) • Indexable input and output registers • Access to textures! – texldl – No dependent read limit
vs_3_0 Outputs • • 12 generic output (on) registers Must declare their semantics up-front like the input registers Can be used for any interpolated quantity (plus point size) There must be one output with the dcl_positiont semantic
vs_3_0 Semantic Declaration • Note that multiple semantics can go into a single output register vs_3_0 dcl_color 4 o 3. x dcl_texcoord 3 o 3. yz dcl_fog o 3. w dcl_tangent o 4. xyz dcl_positiont o 7. xyzw dcl_psize o 6 // color 4 is a semantic name // Different semantics can be packed into one register // positiont must be declared to some unique register // in a vertex shader, with all 4 components // Pointsize cannot have a mask • HLSL currently doesn’t support this multi-packing
Connecting VS to PS 3. 0 Vertex Shader 2. 0 Vertex Shader o 0 o 1 o. Fog o. Pos o 2 o 3 o 4 o 5 o 6 o 7 o 8 o 9 o 10 o 11 o. Pts o. D 0 o. D 1 o. T 0 o. T 1 o. T 2 o. T 3 o. T 4 o. T 5 o. T 6 o. T 7 FFunc Semantic Mapping Triangle Setup v 0 v 1 t 0 t 1 t 2 t 3 t 4 t 5 t 6 t 7 2. 0 Pixel Shader v 0 v 1 v 2 v 3 v 4 v 5 v 6 v 7 v 8 v 9 v. Pos. xy 3. 0 Pixel Shader v. Face
Vertex Texturing in vs_3_0 • With vs_3_0, vertex shaders can sample textures • Many applications – Displacement mapping – Large off-chip matrix palette – Generally cycling processed data (pixels) back into the vertex engine
Vertex Texturing Details • With the texldl instruction, a vs_3_0 shader can access memory • The LOD must be computed by the shader • Four texture sampler stages – D 3 DVERTEXTEXTURESAMPLER 0. . 3 • Use Check. Device. Format() with D 3 DUSAGE_QUERY_VERTEXTEXTURE to determine format support • Look at Vertex. Texture. Filter. Caps to determine filtering support (no Aniso)
2. 0 Pixel Shader HLSL Targets ps_2_0 ps_2_b ps_2_a 64 + 32 512 Temporary Registers 12 32 22 Levels of dependency 4 4 Unlimited Instructions Arbitrary swizzles Predication Static flow control Gradient Instructions
ps_3_0 • • Longer programs (512 minimum) Dynamic flow-control Access to v. Face and v. Pos. xy Centroid interpolation
Aliasing due to Conditionals • Conditionals in pixel shaders can cause aliasing! • You want to avoid doing a hard conditional with a quantity that is key to determining your final color – Do a procedural smoothstep, use a pre-filtered texture for the function you’re expressing or bandlimit the expression – This is a fine art. Huge amounts of effort go into this in the offline world where procedural Render. Man shaders are a staple • On some compile targets, you can find out the screen space derivatives of quantities in the shader for this purpose…
Shader Antialiasing • • • Computing derivatives (actually differences) of shader quantities with respect to screen x, y coordinates is fundamental to procedural shading LOD is calculated automatically based on a 2× 2 pixel quad, so you don’t generally have to think about it, even for dependent texture fetches The HLSL dsx(), dsy() derivative intrinsic functions, available when compiling for ps_2_a and ps_3_0, can compute these derivatives • • Use these derivatives to antialias your procedural shaders or Pass results of dsx() and dsy() to texn. D(s, t, ddx, ddy)
Derivatives and Dynamic Flow Control • The result of a gradient calculation on a computed value (i. e. not an input such as a texture coordinate) inside dynamic flow control is ambiguous when adjacent pixels may go down separate paths • Hence, nothing that requires a derivative of a computed value may exist inside of dynamic flow control – This includes most texture fetches, dsx() and dsy() – texldl and texldd work since you have to compute the LOD or derivatives outside of the dynamic flow control • Render. Man has similar restrictions
v. Face & v. Pos • v. Face – Scalar facingness register – Positive if front facing, negative if back facing – Can do things like two-sided lighting – Appears as either +1 or -1 in HLSL • v. Pos – Screen space position – x, y contain screen space position – z, w are undefined
Centroid Interpolation • • When multisample antialiasing, some pixels are partially covered The pixel shader is run once per pixel Interpolated quantities are generally evaluated at the center of the pixel However, the center of the pixel may lie outside of the primitive Depending on the meaning of the interpolator, this may be bad, due to what is effectively extrapolation beyond the edge of the primitive Centroid interpolation evaluates the interpolated quantity at the centroid of the covered samples Available in ps_2_0 in DX 9. 0 c Pixel Center Sample Location Covered Pixel Center Covered Sample Centroid 4 -Sample One Pixel Buffer
Centroid Usage • When? – Light map paging – Interpolating light vectors – Interpolating basis vectors • Normal, tangent, binormal • How? – Colors already use centroid interpolation automatically – In asm, tag texture coordinate declarations with _centroid – In HLSL, tag appropriate pixel shader input semantics: float 4 main(float 4 v. Tangent : TEXCOORD 0_centroid){}
Summary • Vertex Shaders – Static and Dynamic Flow control • Pixel Shaders – ps_2_x – ps_3_0